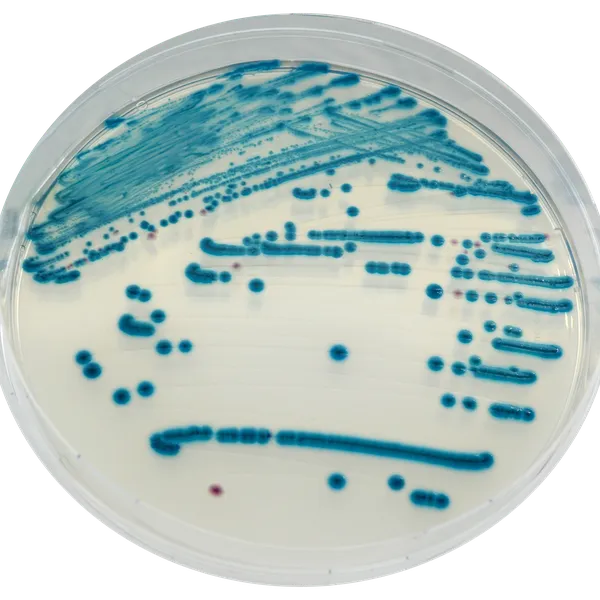
CHROMagar™ STEC

Hình thái khuẩn lạc

Phổ biến nhất Shiga-Toxin
E. coli serotype

Khác Enterobacteriaceae
Không màu, xanh hoặc bị ức chế
Hiệu năng
Hiệu năng
Nhiều nghiên cứu gần đây đã cho thấy rằng, có một số lượng ngày càng tăng và đáng lo ngại của các trường hợp ngộ độc thực phẩm là do non-O157 ShigaToxin-producing E. coli (STEC). CDC cũng đã báo cáo cảnh báo về nguy cơ tiềm tàng này:
"Bệnh gây ra bởi Escherichia coli sản sinh độc tố Shiga (STEC) có thể từ tiêu chảy tự giới hạn đến viêm đại tràng xuất huyết và hội chứng urê huyết tán huyết (HUS). Serotype O157:H7, thường là STEC gây ra viêm đại tràng xuất huyết và HUS, đã được phát hiện từ các vụ ngộ độc thực phẩm lớn, cũng như các trường hợp lẻ tẻ, ở Bắc Mỹ và trên thế giới. Tuy nhiên, 60 serotype STEC đã được chỉ ra là liên quan đến bệnh tiêu chảy, và một số serotype không phải O157:H7 đã được ghi nhận là nguyên nhân gây ra các vụ ngộ độc thực phẩm và HUS ở Hoa Kỳ, Châu Âu, và Úc. Các nghiên cứu từ Canada, Châu Âu, Argentina, và Úc cho thấy nhiễm STEC không phải O157:H7 đang phổ biến ngang với hoặc hơn so với nhiễm O157:H7."
Báo cáo CDC «Sự phổ biến của Non-O157:H7 Shiga Toxin-Producing Escherichia coli trong các mẫu phân tiêu chảy [...]»
Vì thế, một số cơ quan quản lý đã thúc giục ngành công nghiệp thực phẩm toàn cầu thực hiện các biện pháp để kiểm soát sự vắng mặt của các vi sinh vật này trong sản xuất. Trong nhiều trường hợp, các phòng thí nghiệm chỉ giới hạn việc tìm kiếm E. coli gây bệnh trong serotype O157 thông thường. Điều này do, ngoài những lý do khác, việc không có sẵn môi trường nuôi cấy chọn lọc cho E. coli không phải O157.
CHROMagar™ STEC được thiết kế để lấp đầy khoảng trống này: phát hiện, dưới dạng khuẩn lạc màu tím nhạt, không chỉ STEC cổ điển O157 mà còn nhiều serotype khác.
Mục đích sử dụng:
CHROMagar™ STEC là một môi trường nuôi cấy chromogen chọn lọc dùng để phát hiện trực tiếp, phân biệt và nhận dạng sơ bộ các Escherichia coli sản sinh độc tố giống Shiga (STEC), hỗ trợ chẩn đoán nhiễm STEC. Xét nghiệm được thực hiện với mẫu gạc trực tràng và phân. Kết quả có thể được đọc sau 18-24 giờ ủ hiếu khí ở 35-37 °C.
Cần có nuôi cấy đồng thời để phục hồi vi khuẩn cho các xét nghiệm vi sinh tiếp theo hoặc phân loại dịch tễ học. Việc không có sự tăng trưởng hoặc không có khuẩn lạc màu tím nhạt trên CHROMagar™ STEC không loại trừ sự hiện diện của STEC. CHROMagar™ STEC không nhằm chẩn đoán nhiễm trùng cũng như không để hướng dẫn hay theo dõi điều trị cho các nhiễm trùng.
CHROMagar™ STEC cũng có thể được sử dụng để phát hiện STEC trong các phân tích sản phẩm thực phẩm cho người tiêu dùng, thức ăn gia súc và trong các mẫu môi trường.
1. Dễ đọc : Đa số các chủng STEC phát triển thành khuẩn lạc màu tím nhạt, trong khi các vi khuẩn khác có màu xanh dương, không màu hoặc bị ức chế.
3. Ra mắt toàn cầu : Môi trường duy nhất trên thị trường cho phát hiện STEC.
4. Tính linh hoạt : Có thể bổ sung thêm các hợp chất khác để làm cho môi trường này thậm chí còn chọn lọc hơn cho dòng vi khuẩn gây bùng phát.
Thành phần

Tài liệu kỹ thuật
Công bố khoa học
2022
Non-O157 Shiga Toxin producing Escherichia coli (STEC) in Alberta, Canada from 2018-2021
? Publication2020
Evaluation of chromogenic selective agar (CHROMagar STEC) for the direct detection of Shiga toxin-producing Escherichi coli from faecal specimens
? Publication2018
Characterisation of STEC and other diarrheic E. coli isolated on CHROMagar™ STEC at a tertiary referral hospital, Cape Town
? Publication2016
Performance Comparison of CHROMagar™ STEC and the SHIGA TOXIN QUIK CHEK™ assay using a panel of Shiga Toxin Escherichia coli Isolates
? Publication2016
Assessment of commercial chromogenic solid media for the detection of non-O157 Shiga toxin-producing Escherichia coli (STEC)
? Publication2016
Comparison of Agar Media for Detection and Quantification of Shiga Toxin–Producing Escherichia coli in Cattle Feces
? Publication2015
Evaluation of detection methods for non-O157 Shiga toxin-producing Escherichia coli from food
? Publication2015
Comparison of Six Chromogenic Agar Media for the Isolation of a Broad Variety of Non-O157 Shigatoxin-Producing Escherichia coli (STEC) Serogroups
? Publication2014
Evaluation of three ELISA or lateral flow assays and a chromogenic agar to detect shiga toxin-producing E.coli in stool
? Publication2014
Two-step of Shiga-toxigenic Escherichia coli (STEC) with chromogenic media (CGM) and enzyme immunoassay (EIA) from human stool samples
? Publication2013
Evaluation of a new chromogenic agar medium for detection of shiga toxin-producing Escherichia coli (STEC) and relative prevalences of O157 and non O157 STEC in Manitoba, Canada
? Publication2013
Evaluation of Different Commercial Agar Media for the Detection of Shiga Toxin‐ Producing Escherichia coli and the Use of Molecular Typing to Rapidly Identify Serotypes
? Publication2013
Validation of the detection and isolation of verocytotoxigenic E. coli (VTEC) belonging to the serogroups O26, O103, O111 and O145 in beef meat, carcass swabs, fresh vegetables and raw milk according to ISO/TS 13136:2012
? Publication2013
Evaluation of CHROMagar STEC and STEC O104 Chromogenic Agar Media for detection of Shiga Toxin-producing Escherichia coli in stool specimens
? Publication2013
Dramatic change in the apparent epidemiology of Shiga-toxigenic E.coli infection associated with introduction of CHROMagar STEC
? Publication2012
Improving diagnostics of diarrheagenic Escherichia coli by use of a new chromogenic medium
? Publication2012
Evaluation of a new chromogenic agar medium for detection of shiga toxin producing Escherichia coli
? Publication2012
Usability and Performance of CHROMagar STEC Medium in Detection of Shiga Toxin-Producing Escherichia coli Strains
? Publication2011
A rapid procedure for the detection and isolation of enterohaemorrhagic Escherichia coli (EHEC) serogroup O26, O103, O111, O118, O121 and O157 strains and the aggregative EHEC O104:H4 strain from ready-to-eat vegetables
? Publication

Xem thêm